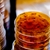

tessa
On Swappa since
Location:
Profile code: UZJ642
0 Reviews • 0 Stars
Sold: 0
Bought: 1
Active: 0
Trust the tech you buy. Swappa verifies listings before they go live.
Latest Reviews

Be the first to rate this seller.
Active Listings
This user has no active listings at the moment.
Disclosure: This site contains affiliate links to other sites. We may receive commissions for purchases made through these links.
Search and Save
Get Help, Fast
Need help with a listing or a sale?
Submit Help RequestHelpful Links
Swappa's typical response time for help requests is around 20 minutes... That's really fast
Sell with Swappa
Cart, Full of Deals
Your cart is empty :(